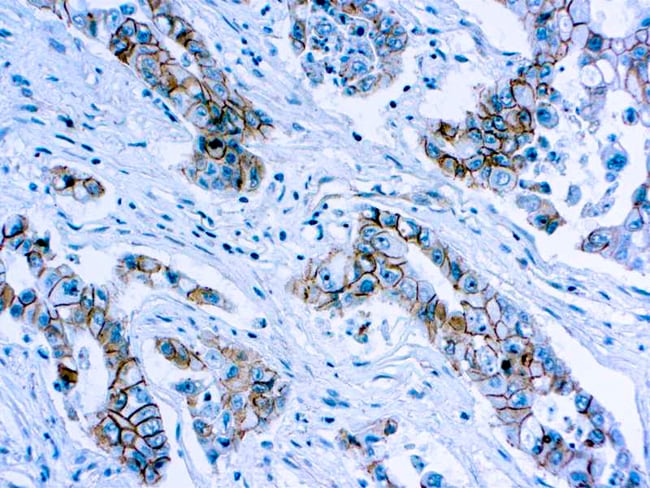
Diagnostic Biosystems BETACATENIN, Quantity Each of 1 Fisher Scientific

La β-catenina è una subunità del complesso proteico della caderina ed è il punto centrale del pathway Wnt\b-catenina, associato alla sopravvivenza cellulare. È codificata dal gene CTNNB1. Nella Drosophila, l'omologa proteina è chiamata armadillo.
La β-catenina fa parte della famiglia delle proteine armadillo, caratterizzata dalla presenza di una serie di domini aminoacidici con capacità di omo – eterodimerizzazione.
Tale proteina svolge numerose funzioni. È importante per la stabilizzazione del citoscheletro e per la stabilità delle giunzioni intercellulari dove interagisce con la caderina o con l'alfa-catenina. Inoltre svolge il ruolo di fattore trascrizionale nella via di segnalazione denominata wingless/Wnt.
Ruolo nella via di segnalazione Wnt\β-catenina
Negli esseri umani, fisiologicamente, in assenza del ligando Wnt, la β-catenina interagisce con un complesso proteico formato da APC, AXIN1, AXIN2, la proteina fosfato 2 e GSK3B. Quest'ultimo fosforila i residui terminali di serina e treonina della β-catenina e ne provoca l'ubiquitinazione con la conseguente degradazione tramite il proteasoma. In presenza del ligando Wnt che interagisce con il recettore di membrana Frizzled, invece, il complesso proteico è inibito e la β-catenina non viene degradata. Quindi essa entra nel nucleo ed interagisce con molti fattori trascrizionali tra cui quelli della famiglia TCF(T-cell factor)/LEF(lymphoid enhancing factor), portando ad attivare i geni responsivi del pathway Wnt. In generale l'attivazione della β-catenina innesca meccanismi di crescita e resistenza all'apoptosi attivando geni c-MYC e la ciclina D1.. In riferimento a quest'ultimo aspetto, il gene che codifica per la β-catenina è considerato un oncogene. Un incremento di β-catenina è sovente riscontrabile nel carcinoma a cellule basali e soprattutto nel cancro del colon-retto.
Altre funzioni
Blocca l'anoikis di cellule tumorali epiteliali derivanti da rene o intestino e promuove la loro crescita ancoraggio-dipendente tramite l'inibizione di DAPK2.
È coinvolta nel pathway CDK2/PTPN6/CTNNB1/CEACAM1 dell'internalizzazione dell'insulina.
Note
Bibliografia
- DeVita, Hellman, Lawrence, DeVita, Hellman, and Rosenberg's Cancer: Principles & Practice of Oncology (8ª edizione), Lippincott Williams & Wilkins, 2008, ISBN 978-0-7817-7207-5.
- Gianni Bonadonna, Gioacchino Robustelli Della Cuna, Pinuccia Valgussa, Medicina oncologica (8ª edizione), Milano, Elsevier Masson, 2007, ISBN 978-88-214-2814-2.
Voci correlate
- Adenomatous Polyposis Coli
- Cancro del colon-retto
- Anoikis
Collegamenti esterni
- Sito cancer.gov; diverse vie sono modulate dal segnale Wnt, su ccr.cancer.gov (archiviato dall'url originale il 26 settembre 2006).
- Sito nih.gov; ruolo della beta-catenina nella trasduzione del segnale Wnt, su mammary.nih.gov. URL consultato il 15 maggio 2009 (archiviato dall'url originale il 22 agosto 2010).
- Sito rochester.edu, processi morbosi della cartilagine nell'artrite, su urmc.rochester.edu (archiviato dall'url originale il 5 settembre 2008).